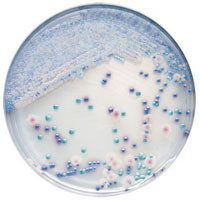

マイストア
変更
お店で受け取る
(送料無料)
配送する
納期目安:
06月13日頃のお届け予定です。
決済方法が、クレジット、代金引換の場合に限ります。その他の決済方法の場合はこちらをご確認ください。
※土・日・祝日の注文の場合や在庫状況によって、商品のお届けにお時間をいただく場合がございます。
憧れの BBL Candida CHROMagar 254093 フロアスタンドの詳細情報
BBL 254093 CHROMagar Candida。Street-Artist Round Blue-Red Glasses | Zeelool Glasses。Amazon.com: Classic Oversize Joplin Style Hippie Round。✨JILLさま専用✨。【商品番号:004】エキゾチックで幻想的なデザインのモザイクガラス製ランプ。Amazon.com: Zeelool Retro Oversized Blue Light Blocking Cat。(スタンドタイプ)変換プラグ付きですので、そのままコンセントに挿してお使い下さい。。【電球はサービスでお付けします。フロアランプ ブラック×ホワイト。】生産国:トルコサイズ:高さ 約49㎝、ランプガラス直径 約16㎝材質:ガラス・真鍮・ビーズ・石膏色(点灯時):オレンジ電球:口金E14電源:家庭用電源100V※手作りの為、神経質な方はご遠慮願います。10本セット ブランチツリー LED ツリーライト 北欧風 クリスマス 間接照明。#トルコ#モザイクランプ#モザイクガラス#インテリア#オリエンタル#エキゾチック#幻想的#お洒落#間接照明#スタンドランプ#寝室#リビング#玄関
ベストセラーランキングです
近くの売り場の商品
カスタマーレビュー
オススメ度 4.2点
現在、3152件のレビューが投稿されています。

























